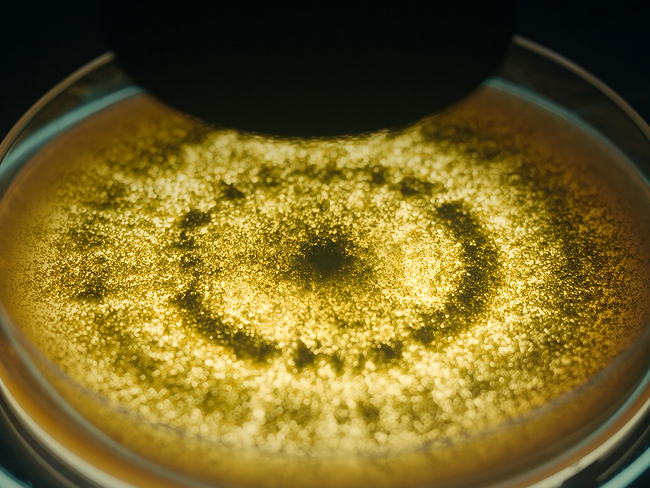

源头严控
好原料是“质”的根基
我们坚信“原料决定上限”,让好原料成为好产品的第一块基石。
为此我们构建了从“种植-检测-运输-仓储”的全链条闭环品控与透明溯源体系:
规模筑基
大产能成就“低成本”竞争力

从广东佛山出发
我们已在
江苏宿迁 · 广西南宁 · 湖北武汉
等城市布局现代化生产基地

形成超60万平方米的生产集群,年总产能突破450万吨,
用“全国布局+产能规模”,让高品质与低成本同时兼得。
科技赋能
硬核实力夯实“质”的壁垒
公司每年将3%的营收持续投入到科研中,近十年,我们在科研方面已投入59亿元,以技术创新重构生产标准。历经70年迭代选育的“海天菌”领先行业水平,发酵更充分、风味更纯正。自主研发核心酿造设备,突破国外技术封锁,生产过程更安全、品质更稳定。
智能智造
精益管理释放“性价比”潜能
2025年,海天获评全球酿造调味品行业首家“灯塔工厂”,以灯塔为标杆,通过“智能制造+精益管理”,形成“高质量+低成本”的可量化可复制标准,通过智能排产、能耗优化等系统,使生产损耗降低、能源利用率提升,实现高质价比的稳定输出。

*世界经济论坛“灯塔工厂”
智能检测全力护航

在线NIR光谱分析
实时监测各项过程指标,
一点一滴都是精心酿制

AI电子鼻
提升成品品鉴准确度,
让美味成为唯一的出厂标准

AI精准灌装系统
实现无滴漏灌装,全程零接触、无外露,确保每一瓶产品洁净安全、品质如一

全渠道覆盖
立体网络全面触达
渠道覆盖全100%地级市、90%县级市场,深度渗透餐饮、商超、电商等多元场景,通过全国渠道伙伴协同运作,构建起“线下深度覆盖 + 线上精细渗透”的全渠道立体通路。

智慧速达,定制仓配
灵活适配,性价比拉满
依托四大产业园及区域仓库,搭配高度智能化的控温控湿仓储系统和分拣系统,提供融合多式联运(公路/铁路/海运)与绿色运输(低碳减排)的一站式定制化仓配解决方案,实现成本与时效的最佳组合。
极速定制能力

原型开发快
国家级调味品工程中心主导,标准化研发流程实现“72小时从创意→产品原型”的高效转化,确保定制产品风味稳定、工艺精准、贴合市场

生产交付快
全流程柔性自动化产线支持“多品种小批量”订单“零切换”生产,实时库存优化+“随需随产”模式,最快3天完成定制打样、7天交付成品,抢占市场先机。
全周期专业赋能

餐调定制
累计服务超5000个餐饮品牌,从名厨风味调试、门店应用培训到营销推广支持,提供“研发-生产-运营”全链路赋能。

食品工业
深度解决客户工艺痛点,助力生产效率提升,保障稳定生产。

OEM/ODM
服务多家头部零售大客户,从配方研发到包装设计全链路支持,以“市场洞察+技术落地”能力,共同打造“适销爆款”。